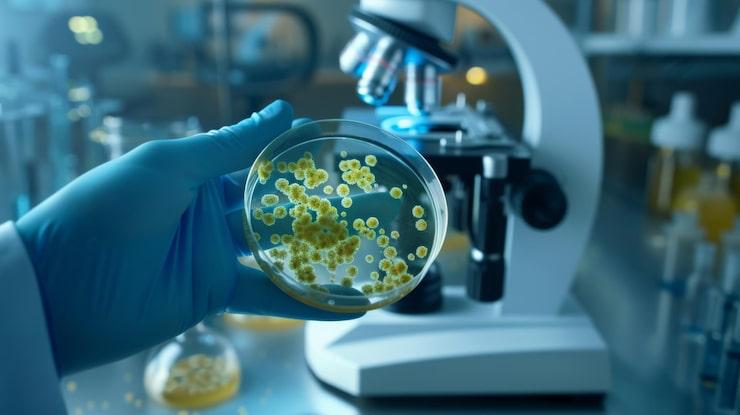
Anti-Microbial assays

We deliver Next-Gen Research Services
Get In Touch With Us1000 +
Researchs2 +
Advanced Laboratory150 +
Happy Customers
Welcome to Narensnosh Pvt Ltd
Our company is dedicated to providing comprehensive food sample analysis services with a strong focus on accuracy, reliability, and innovation. We specialize in ensuring the safety, quality, and authenticity of food products by employing advanced analytical techniques and state-of-the-art instrumentation. With a team of skilled professionals, we are committed to delivering results that help industries comply with national and international standards while safeguarding consumer trust.
Beyond testing, we strive to be a partner in progress for food businesses, research institutions, and startups. By combining scientific expertise with ethical practices, we aim to support the development of safe, sustainable, and high-quality food products. Our vision is to create a healthier future where every consumer has access to food that is authentic, nutritious, and free from harm.
Our Research Areas
We are committed to advancing knowledge and innovation across diverse scientific domains. Our research is designed to address real-world challenges while building trust through transparency and rigor.
Read Top Articles

Lorem ipsum dolor sit amet
Lorem ipsum dolor sit amet, consectetur adipiscing elit.

Lorem ipsum dolor sit amet (1)
Lorem ipsum dolor sit amet, consectetur adipiscing elit.

Lorem ipsum dolor sit amet (2)
Lorem ipsum dolor sit amet, consectetur adipiscing elit.

Lorem ipsum dolor sit amet (3)
Lorem ipsum dolor sit amet, consectetur adipiscing elit.
Cutting-Edge Science, Reliable Results
At our laboratory, innovation meets precision. We combine state-of-the-art technology with world-class expertise to deliver results you can trust - fast, accurate, and dependable. Whether it’s advanced diagnostics, research support, or specialized testing, our team ensures every analysis meets the highest standards of quality.

Dr. Ananya Sharma, Cardiologist, New Delhi
The accuracy and speed of results from this laboratory have been outstanding. As a healthcare professional, I rely on timely diagnostics, and their team has never let me down.
Prof. Raghav Menon, Research Scientist, Bengaluru
We partnered with the lab for our research on nutraceuticals, and the level of detail in their analysis was exceptional. Their commitment to quality gave us complete confidence in our findings.
Priya Nair, Mysore
From routine blood tests to specialized assays, the service has always been reliable. The staff is courteous, and the reports are clear and easy to understand.
Dr. Arvind Patel, Clinical Researcher, Hyderabad
Our pharmaceutical trials required precise cell culture analysis, and this lab delivered beyond expectations. Their professionalism and advanced technology truly set them apart.
Meera Iyer, Nutrition Consultant, Chennai
I appreciate the transparency and trust this laboratory brings to every test. Their dedication to science and integrity makes them our preferred partner.